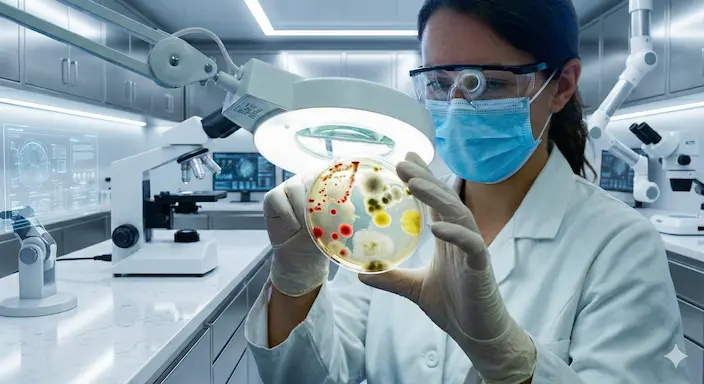

No dejes que el ardor y las molestias controlen tus días. Obtén un diagnóstico certero y un tratamiento que erradique las infecciones desde la raíz.
Aviso Médico Importante: Esta información es de carácter estrictamente educativo y divulgativo. En ningún caso sustituye el diagnóstico, la evaluación clínica ni el consejo experto y personalizado de un médico urólogo certificado. Ante cualquier síntoma, acuda a consulta presencial.
Fuentes de Consulta Sugeridas: Para profundizar, le invitamos a consultar las guías oficiales para pacientes de la Asociación Americana de Urología (AUA), la Asociación Europea de Urología (EAU), o los recursos bibliográficos de la Clínica Mayo.
* Nota sobre recursos visuales: Las imágenes utilizadas en este diseño han sido obtenidas de bancos de imágenes y/o creadas total o parcialmente utilizando tecnologías de Inteligencia Artificial con fines puramente ilustrativos.
© 2026 Dr. Habid Becerra. Puerto Vallarta, Jalisco, México. Todos los derechos reservados.
Aviso de Privacidad